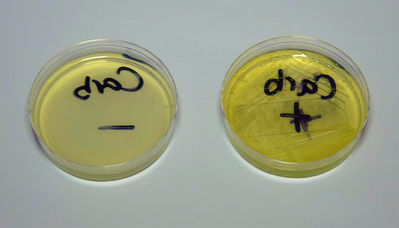
阳性结果：只有抗性菌株生长基（右）
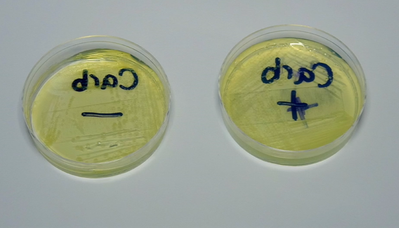
阴性结果 1：两种菌株均生长
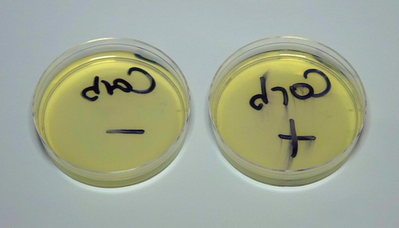
阴性结果2：两种菌株均未生长

分子实验笔记07:质粒转入菌体后,固体培养筛选的一般流程
来源:武汉市灰藻生物科技有限公司 浏览量:27 发布时间:2026-01-18 14:47:40
引言(Introduction)
质粒(plasmids)可携带一个或多个抗生素抗性基因(antibiotic resistance genes),赋予携带该质粒的细菌对特定抗生素的抗性。利用这一特性,研究人员可通过人工选择(artificial selection)——即在含抗生素的培养基中培养细菌——轻松地从不含质粒的细菌中筛选出含有目标质粒的菌株。
Luria肉汤(Luria broth, LB)是一种营养丰富的培养基,广泛用于实验室细菌培养。向LB中加入琼脂(agar)后,会形成凝胶状固体培养基:细菌虽无法消化琼脂,但可从中摄取LB提供的营养物质。若在此凝胶中添加抗生素,则仅允许携带相应抗性基因(通常由质粒提供)的细菌生长,从而实现高效筛选。以下操作流程将指导您自行配制含所需抗生素的LB/琼脂平板。
设备(Equipment)
- 高压灭菌锅(Autoclave)
- 水浴锅(Water bath)
- 移液器(Pipettor)
试剂(Reagents)
- 预混LB-琼脂粉 37 g/L,成分包括:
- 1 L 无菌水(Sterile H₂O)
- 所需规格的无菌培养皿(Sterile plates)——我们通常使用 60 mm × 15 mm 培养皿,可容纳 5–10 mL 琼脂,最多可清晰分辨约100个单菌落。
专业提示(Pro-Tip):若需筛选大量菌落,建议使用更大规格的培养皿。许多实验室采用 100 mm × 15 mm 培养皿,可容纳 10–25 mL 琼脂。
- 可高压灭菌的锥形瓶(Autoclavable flasks)
- 无菌移液管(Sterile pipettes)
- 盛放抗生素的冰盒(Ice bucket to hold antibiotic)
- 1000× 抗生素母液(Antibiotic at 1000× concentration),溶于合适的溶剂(参见下方表格)
抗生素浓度推荐表(Antibiotic Concentrations)
| 抗生素(Antibiotic) | 推荐母液浓度(Recommended Stock Concentration) | 推荐工作浓度(Recommended Working Concentration) |
|---|---|---|
| Ampicillin(氨苄青霉素) | 100 mg/mL | 100 µg/mL |
| Bleocin(博来霉素) | 5 mg/mL | 5 µg/mL |
| Carbenicillin*(羧苄青霉素) | 100 mg/mL | 100 µg/mL |
| Chloramphenicol(氯霉素) (溶于乙醇 EtOH) | 25 mg/mL | 25 µg/mL |
| Coumermycin(香豆霉素) (溶于DMSO) | 25 mg/mL | 25 µg/mL |
| Gentamycin(庆大霉素) | 10 mg/mL | 10 µg/mL |
| Kanamycin(卡那霉素) | 50 mg/mL | 50 µg/mL |
| Spectinomycin(壮观霉素) | 50 mg/mL | 50 µg/mL |
| Tetracycline(四环素) | 10 mg/mL | 10 µg/mL |
注:除非另有说明,抗生素粉末通常溶于去离子水(dH₂O)。
* 羧苄青霉素(Carbenicillin)可替代氨苄青霉素。其化学性质更稳定,能更有效地筛选含目标质粒的细菌(例如减少“卫星菌落” satellite colonies 的出现),但价格更高。
操作步骤(Procedure)
1. 按每升熔融琼脂称取37 g预混LB-琼脂粉。
实际称量质量取决于您计划倒制的平板数量。
示例:若需制备20块平板,每块最多加10 mL,则共需200 mL培养基。
为防止洒漏或计量误差,建议多配约10%(如220 mL)。
因此,220 mL LB-琼脂所需粉末量为:
(37 g/L) × 0.220 L = 8.14 g。
2. 将称好的LB-琼脂粉转移至合适体积的耐压瓶中用于高压灭菌。
例如:400 mL琼脂用1 L瓶,200 mL用500 mL瓶。预留足够空间以防灭菌时沸腾溢出。
3. 向瓶中加入对应体积的无菌水(本例为220 mL),轻轻旋摇形成均匀胶体。
4. 用瓶盖或铝箔 loosely 覆盖瓶口(切勿密封!),贴上高压灭菌指示胶带。
该胶带在121°C维持10分钟以上会变色。另用实验室胶带标注姓名、日期及内容物,避免遗忘在灭菌锅内造成混淆。
5. 将混合液放入高压灭菌锅,在20 psi下于121°C灭菌至少30分钟。
高压可防止高温下液体沸腾溢出。
专业提示:尽管此条件可杀灭大多数污染物,但某些芽孢(spores)可能存活。若处理特殊微生物,请查阅文献确认合适的灭菌方法。
6. 灭菌期间,准备倒板工作站:
- 选择带酒精灯的洁净实验台区域;
- 用70%乙醇喷洒台面并用纸巾擦拭;
- 清点所需数量的培养皿并堆叠放置;
- 在皿底标注日期、培养基类型及所用抗生素名称。
专业提示:我们使用彩色记号笔批量标记——不同颜色对应不同抗生素。
- 将酒精灯置于倒板区域一侧,留出空间放置熔融琼脂瓶、抗生素管架及操作区。
7. 配制抗生素母液。
在加入熔融琼脂前,需先配制1000×母液。
示例:若工作浓度为100 µg/mL氨苄青霉素,则母液浓度应为100 mg/mL(即100,000 µg/mL)。称取100 mg粉末溶于1 mL水,涡旋溶解后经滤膜除菌。
8. 准备60°C水浴,水量需能浸没琼脂瓶约75%高度。
专业提示:60°C是理想温度——琼脂仍为液态,而多数抗生素在此温度下稳定。请根据具体抗生素说明书确认。
9. 从高压灭菌锅中取出熔融琼脂。
专业提示:灭菌结束后,建议将锅门微开约10分钟,释放蒸汽并初步降温。取出时务必佩戴隔热手套!
10. 将琼脂瓶部分浸入60°C水浴中至少5分钟。
专业提示:切勿让水浴水接触瓶口(非无菌)。冷却后的琼脂应温热但不烫手——若戴普通实验手套无法直接拿取,则温度仍过高。建议使用激光测温枪确认温度。
11. 点燃酒精灯,采用无菌操作将抗生素母液加入约60°C的熔融琼脂中。
12. 轻柔旋摇琼脂瓶,确保抗生素均匀分布。
13. 在火焰旁逐个打开培养皿,开始倒板。
首块平板可用移液器量取目标体积(如5–10 mL),以熟悉该体积在皿中的覆盖效果。
14. 后续平板可直接从瓶中倾倒。
专业提示:
• 倒板后轻旋培养皿以消除气泡并使琼脂均匀铺平;
• 每倒完一块立即盖好并堆叠。
• 若倒板过程中琼脂在瓶中开始凝固,应停止操作并重新配制。若未加抗生素,可再次高压灭菌或微波加热复溶(注意防暴沸!)。
15. 将平板置于实验台静置凝固。
专业提示:室温下约30分钟凝固,但我们通常过夜晾干以减少冷凝水。干燥后装入含吸水材料的塑料袋,4°C保存备用。
16. 平板凝固干燥后,需进行抗生素功能验证:
- 取两块新制平板;
- 第一块划线接种已知抗性菌株;
- 第二块划线接种非抗性菌株;
- 于适宜温度过夜培养,观察生长情况(参见下方示例数据)。
示例数据(Sample Data)
以下结果中,“(–)”表示测试菌株不应具有抗性,“(+)”表示应具有抗性。
图1:阳性结果:只有抗性菌株生长
✅ 阳性结果:仅抗性菌株生长
若操作正确,应仅见抗性菌株生长。此时平板可用于实验或4°C保存。注意:平板保存不应超过1个月,使用前需检查是否污染。
图2:阴性结果 1:两种菌株均生长
❌ 阴性结果1:两种菌株均生长
若划线菌株正确,则可能原因:
- 抗生素已降解;
- 忘记添加抗生素;
- 抗生素浓度过低,无法有效筛选。
图3:阴性结果2:两种菌株均未生长
❌ 阴性结果2:两种菌株均不生长
可能原因:
- 使用了错误的抗生素;
- 抗生素浓度过高,抑制了所有菌株;
- 一种或两种菌株已失活。验证方法:将两株菌分别划线于不含抗生素的LB平板,确认其活性。

图4:阴性结果3:仅非抗性菌株生长
❌ 阴性结果3:仅非抗性菌株生长
极可能原因:使用了错误的抗生素,或混淆了菌株。
参考文献
https://www.addgene.org/
敬请关注灰藻生物,共筑健康未来!
— 武汉市灰藻生物科技有限公司团队敬上
灰藻生物:我们期待着与客户共同成长,共创生命科学的美好未来!
更新日期:2026-01-18
编制人:磊子
审稿人:小藻